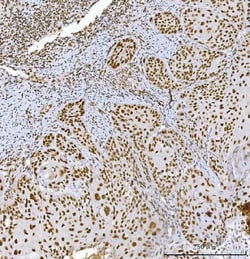
Invitrogen RCC1 Monoclonal Antibody (6B11E7) 100 &mu;g; Unconjugated:Antibodies,

Learn More
Invitrogen™ RCC1 Monoclonal Antibody (6B11E7)


Mouse Monoclonal Antibody
Brand: Invitrogen™ MA549237
Description
Adding 0.2 mL of distilled water will yield a concentration of 500 μg/mL. Positive Control - WB: human 293T whole cell, human A431 whole cell, human HepG2 whole cell, human Raji whole cell. IHC: human thyroiditis tissue, human colorectal adenocarcinoma tissue, human breast cancer tissue, human spleen tissue, human squamous cell lung carcinoma tissue. ICC/IF: A431 cell. Store at -20°C for one year from date of receipt. After reconstitution, at 4°C for one month. It can also be aliquotted and stored frozen at -20°C for six months. Avoid repeated freeze-thaw cycles.
Guanine-nucleotide releasing factor that promotes the exchange of Ran-bound GDP by GTP. Involved in the regulation of onset of chromosome condensation in the S phase. Binds both to the nucleosomes and double-stranded DNA. RCC1-Ran complex (together with other proteins) acts as a component of a signal transmission pathway that detects unreplicated DNA. Plays a key role in nucleo-cytoplasmic transport, mitosis and nuclear-envelope assembly.
Specifications
| RCC1 | |
| Monoclonal | |
| 500 μg/mL | |
| PBS with 4mg trehalose and no preservative | |
| P18754 | |
| RCC1 | |
| E.coli-derived human RCC1 recombinant protein (Position: A14-S421). | |
| 100 μg | |
| Primary | |
| Human | |
| Antibody | |
| IgG2a |
| Immunohistochemistry (Paraffin), Western Blot, Immunocytochemistry | |
| 6B11E7 | |
| Unconjugated | |
| RCC1 | |
| 4931417M11Rik; AI326872; Cell cycle regulatory protein; chc1; chc1-a; chromosome condensation 1; chromosome condensation protein 1; fj77f08; guanine nucleotide-releasing protein; RanGEF; RCC1; rcc1.L; rcc1-a; rcc1-b; RCC1-I; Regulator of chromosome condensation; regulator of chromosome condensation 1; regulator of chromosome condensation 1 L homeolog; SNHG3-RCC1; SNHG3-RCC1 readthrough; wu:fj77f08; XELAEV_18012073mg; xrcc1; zgc:65796; zgc:77114 | |
| Mouse | |
| Antigen affinity chromatography | |
| RUO | |
| 1104 | |
| -20°C | |
| Lyophilized |
Your input is important to us. Please complete this form to provide feedback related to the content on this product.